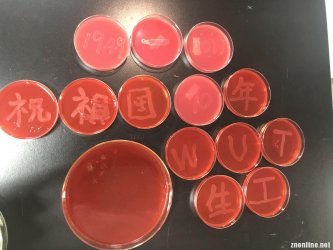

10月3日消息(通讯员 汪巧园 报道)“1949-2019祝中华人民共和国成立70周年生日快乐!”是唐瑞琪对中华人民共和国成立70周年最诚挚的告白,培养基上一个个初现形状的痕迹都是他反复多次实验后的成果。在中华人民共和国成立70周年之际,武昌理工学院生物工程专业1801班唐瑞琪同学一份特别的礼物引起学院老师和同学的高度关注,他以红色培养基为底色,黄色菌群为点缀构成五星红旗形状来培养细菌,以此祝贺祖国生日快乐。
据唐瑞琪介绍,9月27号他在实验室做实验的时候看到同班同学王昊宇在进行纤维素分解菌的实验时,他们的培养基是红色的,然后就突发奇想:能不能做一个红色的培养基在上面种上一种黄色的菌,做一个五星红旗一样的东西?然后两个人就开始去找培养基的染色剂,他们试了刚果红,番红,中性红好几种染色剂最后决定用刚果红去对培养基进行染色。而培养基上黄色的菌17级的学长学姐给了很多建议,最后生物工程系主任代建丽老师给了他们建议,用金黄色葡萄球菌来做黄色的星。
28号他们就开始进行试验,前一天养的菌没有长出来黄色的,他们又去实验室里找金葡的斜面进行醒菌摇菌,并开始做第一次的预实验。“结果并不是很理想,我们低估了五星红旗的难度,那五角星的标志我们并不难很好的控制,所以我们改变计划说看能不能写一两字来表达我们的情感。”实验中唐瑞琪也曾苦恼过。29号他们开始了涂菌,共做了50个平板,他们甚至做到了晚上10点。“虽然菌落长出来并不是我们预计中的亮黄色而是黄白色,但我们对祖国的祝福之情永远不会褪色。”他们团队的另一成员王紫雯说到。
最后唐瑞琪告诉记者道:“今年是中华人民共和国成立70周年,就在29号袁隆平院士和屠呦呦院士两位大佬级人物,步入人民大会堂,接受来自祖国的认可—‘国家勋章’。而这两位老人应该是我们全生科学子的目标,是全生科学子的榜样。也许我们学的东西,我们做的实验跟他们云泥之别,但我们对祖国的热爱,希望祖国繁荣昌盛的心是一样。在此中华人民共和国成立70周年之际希望生科学子能很好好学习天天向上,像两位院士学习,做一个对祖国有用的人,做祖国的栋梁之才!”(完)
中南在线 http://znonline.wut.edu.cn/html/xinwen/jingjingxiaoyuan/2019/1001/86932.html